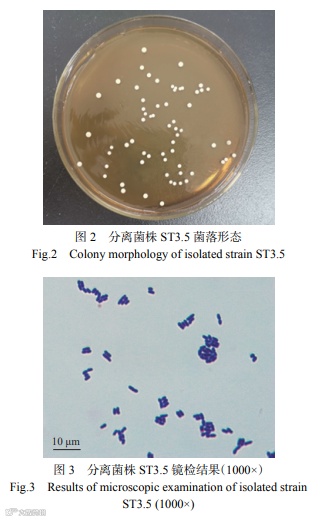

图片来源于图司机
黑龙江八一农垦大学张丽媛教授等拟从泡菜中筛选出一株植物乳杆菌并研究其生物特性,探究该菌株对从玉米中分离的产黄青霉和杂色曲霉的抑制作用,分析其抑制霉菌的主要物质,为乳酸菌作为生物抑菌剂在谷物等食品的储藏及运输过程中的应用提供理论依据,以减少因食物霉变造成的经济损失和对消费者健康的潜在危害。
从泡菜中分离获得34株分离菌株。分别以产黄青霉和杂色曲霉作为测试菌,通过琼脂覆盖法测定34株分离菌株对产黄青霉和杂色曲霉的抑制作用。如表1所示,菌株ST3.5的抑制效果最好。由图1可知,与对照组相比较,接种的乳酸菌条带具有显著的抑制作用,其抑菌圈覆盖面积超过50%,表明菌株ST3.5对产黄青霉和杂色曲霉均具有较强的抑菌效果。

如图2显示,分离菌株ST3.5单菌落直径较小,呈规则圆形且表面光滑湿润;大部分为白色或乳白色,少数为半透明;挑取时具有一定黏性。革兰氏染色镜检结果显示(图3),菌株为革兰氏阳性菌,菌体呈杆状较短。从图4可以看出,该菌株的16S rRNA基因序列与植物乳杆菌(Lactiplantibacillus plantarum)具有97%以上的同源性,因此,该菌株为一种植物乳杆菌(L. plantarum)。

L. plantarum ST3.5的生长曲线和pH变化曲线如图5,由图可见,该菌株在测定时间内OD值先迅速增加后趋于平稳。在2 h左右,因为有充足营养物质,所以乳酸菌迅速进入对数生长期,开始大量繁殖,同时OD600 nm值增加,在16 h左右,随着乳酸菌的生长和繁殖,产生了大量的代谢产物,大量的营养物质被消耗殆尽,随后停止了对数生长,进入了稳定期,并且在16~24 h期间OD值均保持稳定。由于乳酸菌生长会产生酸性物质,所以L. plantarum ST3.5前16 h的pH从6.25迅速下降到4.51,在16~24 h期间乳酸菌停止生长和繁殖,所以pH无显著变化(P>0.05),趋于稳定。

正常健康人体的空腹胃液pH约为1.3~2.0,进食半小时后约为3.0~5.0。益生菌要在肠道中发挥作用的前提是须在pH3.0左右的条件下存活1.5~2 h。另外,人体小肠内胆盐浓度在0.3~3.0 g/L 之间。高浓度的胆盐会改变菌体细胞膜的通透性,分解膜蛋白,使细胞破裂死亡,从而拮抗益生菌的生长。L. plantarum ST3.5对酸和胆盐的耐受性如表2所示,从表中可知在不同pH的培养基中培养3 h后,随着pH的降低,ST3.5活菌数越来越少,当pH为3时,活菌数为(9.33±0.21)log CFU/mL,当pH为2时,活菌数为(4.48±0.00)log CFU/mL。在不同胆盐浓度的培养基中培养时,随着胆盐浓度的升高,ST3.5的活菌数逐渐下降,在0.1%浓度中活菌数为(9.31±0.05)log CFU/mL,0.2%中为(6.09±0.98)log CFU/mL,而浓度升高到0.3%时,未检测到活菌。说明ST3.5有较好的耐酸性,但对胆盐的耐受效果一般,以上结果与肖俊等的研究相似。而郑越等的研究表示不同植物乳杆菌菌株的耐酸耐胆盐能力有一定差异,可能是因为不同菌株之间生物酶、脂肪酸等代谢物的种类和含量不同,影响代谢途径,导致菌株间耐酸、耐胆盐能力的差异。


抗生素敏感性是选择益生菌菌株的前提之一,乳酸菌具有广谱的天然和获得性抗生素抗性,并且不同菌株对抗生素的耐药性不同。如表4结果可知,L. plantarum ST3.5对阿米卡星、红霉素、头孢呋辛、多西环素、氨苄西林、氯霉素、利福平等抗生素敏感,对庆大霉素、头孢噻肟、四环素、青霉素、环丙沙星等具有耐药性。所以,为了降低对有益菌的影响,使用时应该尽可能地避免使用敏感性的药物。王楠等的研究表明植物乳杆菌Y190430对氨苄西林、多西环素、氯霉素、红霉素等抗生素类药物敏感。研究发现乳酸菌对青霉素和头孢噻肟耐药是因为乳酸菌产生的β-内酰胺酶抑制青霉素与头孢菌素结合蛋白造成的;对卡那霉素、链霉素、庆大霉素有天然耐药性,是由缺乏细胞色素介导的电子传递而引起的。有研究表明,存在肠道菌群之间的耐药基因会发生转移现象,一些对常见抗生素耐药的乳酸菌,会将耐药基因经由食物链传播到其它肠道和呼吸道的病原体,使致病菌产生耐药性,对机体造成危害。








《食品工业科技》特邀主编专栏征稿
《食品工业科技》青年编委专栏征稿:生物基材料在食品包装领域的应用 ☚
《食品工业科技》特邀主编专栏征稿:食品中天然产物提取分离、结构表征和生物活性 ☚
《食品工业科技》青年编委专栏征稿:枸杞、红枣、沙棘等食药同源健康食品研究与开发 ☚
《食品工业科技》青年编委专栏征稿:AI for Food Industry:人工智能在食品工业中的应用 ☚
群聊:食品工业科技作者群

温
馨
提
示

我刊正式组建微信作者群,为作者提供更多的学术与论文资讯,如需进群,请联系刘老师(微信:上方二维码,电话:87244117-8062)。

版权声明








